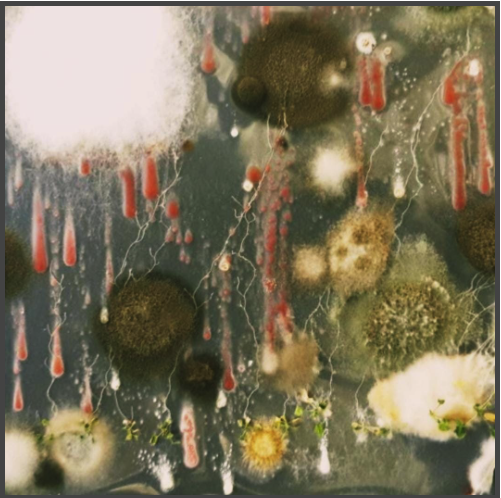
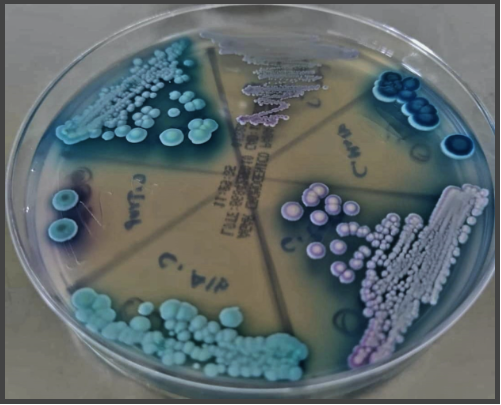

Concurso de Fotografía Científica: ciencia bajo el foco
Resultados
Agradecemos a todos(as)su participación para este Primer Concurso de Fotografía Científica: ciencia bajo el foco.
Felicitamos a los ganadores:
Categoría: Microcosmos asombroso
Itzel Amasende Morales
Primer Lugar
Título : Gameta
Descripción: "El sistema reproductivo femenino de plantas con flores: un organismo enigmático". Micrografía de un gameto femenino de frijol caupí, tomada con un microscopio confocal, en magenta núcleos teñidos y en azul, paredes celulares teñidas.

David Alberto Garcia Estrada
Participantes
Título: Los esclerocios, estructuras de supervivencia
Descripción: Sclerotium rolfsii es un hongo filamentoso patógeno de una amplia gama de plantas. Este hongo no forma esporas ni estructuras fructíferas sexuales, en cambio, produce esclerocios que comienzan a formarse a partir de la acumulación de mechones de micelio blanco que van dar lugar a esas bolitas de un diámetro de 0.5 a 1.5 mm. Estos esclerocios se oscurecen a medida que maduran y se vuelven color canela a marrón oscuro. Estas estructuras le permiten al hongo sobrevivir por largos periodos de tiempo en restos culturales de plantas y suelos, germinando cuando perciben condiciones idóneas para vivir.
Fotografía de Sclerotium rolfsii que creció y se desarrolló en placa de PDA.

Blanca Susana Ruiz Castro
Participante
Título: Levadura de pan vista al microscopio óptico
Descripción: Cepas de levadura utilizadas comúnmente como un agente de levadura para pan y productos de panadería, donde los azúcares fermentables presentes en la masa se convierten en dióxido de carbono y etanol. La levadura de panadero es de la especie Saccharomyces.

Blanca Susana Ruiz Castro
Participante
Título: Estructuras macroconidios de Fusarium equiseti, vistas al microscopio óptico 100X
Descripción: Es un hongo de suelo, causantes del "Damping off". Siendo un hongo saprofítico, los ataques pueden producirse por inóculo presente en el suelo o en la semilla.
Este fue aislado de raíces y coronas de plantas de fresa en el laboratorio.

Nestor Daniel Ramos Camacho
Participante
Título: Microbioestelar
Descripción: En la ciencia, el cultivo in vitro permite controlar las condiciones a las que planeamos crecer algún organismo específico. Sin embargo, en algunas ocasiones la naturaleza fluye y nos muestra su magia. (Caja de petri con medio MS contaminado).
Categoría: Mundos macroscópicos
David Alberto Garcia Estrada
Primer Lugar
Título: Aros de fotoconidiación
Descripción: Trichoderma atroviride es un hongo filamentoso benéfico de las plantas. Es un hongo cosmopolita que lo encontramos principalmente en la rizosfera de las plantas. Tiene la virtud de mejorar el crecimiento de las plantas mediante diversos compuestos que libera y, por otro lado, tiene la capacidad de matar a otros patógenos de la planta, sirviendo como un defensor de ellas. T. atroviride es un hongo modelo para el estudio de la percepción de la luz y daño, ya que tiene la capacidad de conidiar cuando percibe un pulso de luz azul o recibe un daño sobre su micelio. Estas conidias son estructuras que posteriormente se pueden propagar para volver a germinar y así sobrevivir como especie.
Fotografía de Trichoderma atroviride que creció y se desarrolló en placa de PDA, que fue expuesta la luz en diferentes momentos, cada uno de ellos genera estos aros verdes que son conidias producidas en respuesta al estímulo de la luz.

Héctor Guillén Alonso
Participante
Título: Elucidando distribución metabólica de Beauveria pseudobassiana
Descripción: Escaneo superficial de Beauveria pseudobassiana (crecido por Verónica Frias Negrete), para conocer la distribución de sus metabolismos utilizando espectrometría de masas con ionización ambiental, instrumentos desarrollados en el laboratorio del Dr. Robert Winkler. La técnica consiste en utilizar un robot (desarrollo del laboratorio) que mueve la muestra para su escaneo, mientras que un láser ablaciona la superficie de la muestra, al mismo tiempo que las moléculas liberadas son ionizadas por un plasma de baja temperatura impreso en 3D (desarrollo del laboratorio), los iones entran al espectrómetro de masas y un software (desarrollo del laboratorio) analiza los datos y los muestra en la pantalla en forma de una imagen que muestra la distribución de los metabolitos detectados, el software elimina las moléculas que se encuentran en el ambiente.

Blanca Susana Ruiz Castro
Participante
Título: Placa de agar cromo con cepas de cándida
Descripción: Es un método de diferenciación de microrganismos basado en colores, aquí presentamos diferentes especies de cándidas reaccionando al color.
Héctor Guillén Alonso
Participante
Título: Spray en papel para el análisis de sangre de alta velocidad
Descripción: Análisis automatizado de una gota de sangre sin la necesidad de preparación de la muestra utilizando espectrometría de masas con ionización ambiental, método desarrollado en el laboratorio del Dr. Robert Winkler. Un robot (desarrollo del laboratorio) toma una rejilla con ocho cartuchos y los coloca sobre la superficie de análisis, cada cartucho contiene una gota de sangre seca, en la parte trasera se le agrega una gota de solvente y a medio cartucho se conecta un electrodo de alto voltaje que ioniza la muestra en la entrada del espectrómetro de masas. Comparado con técnicas convencionales se logra reducir el tiempo de análisis más de 60 veces, el coste de la prueba hasta seis veces y la capacitación del personal.
